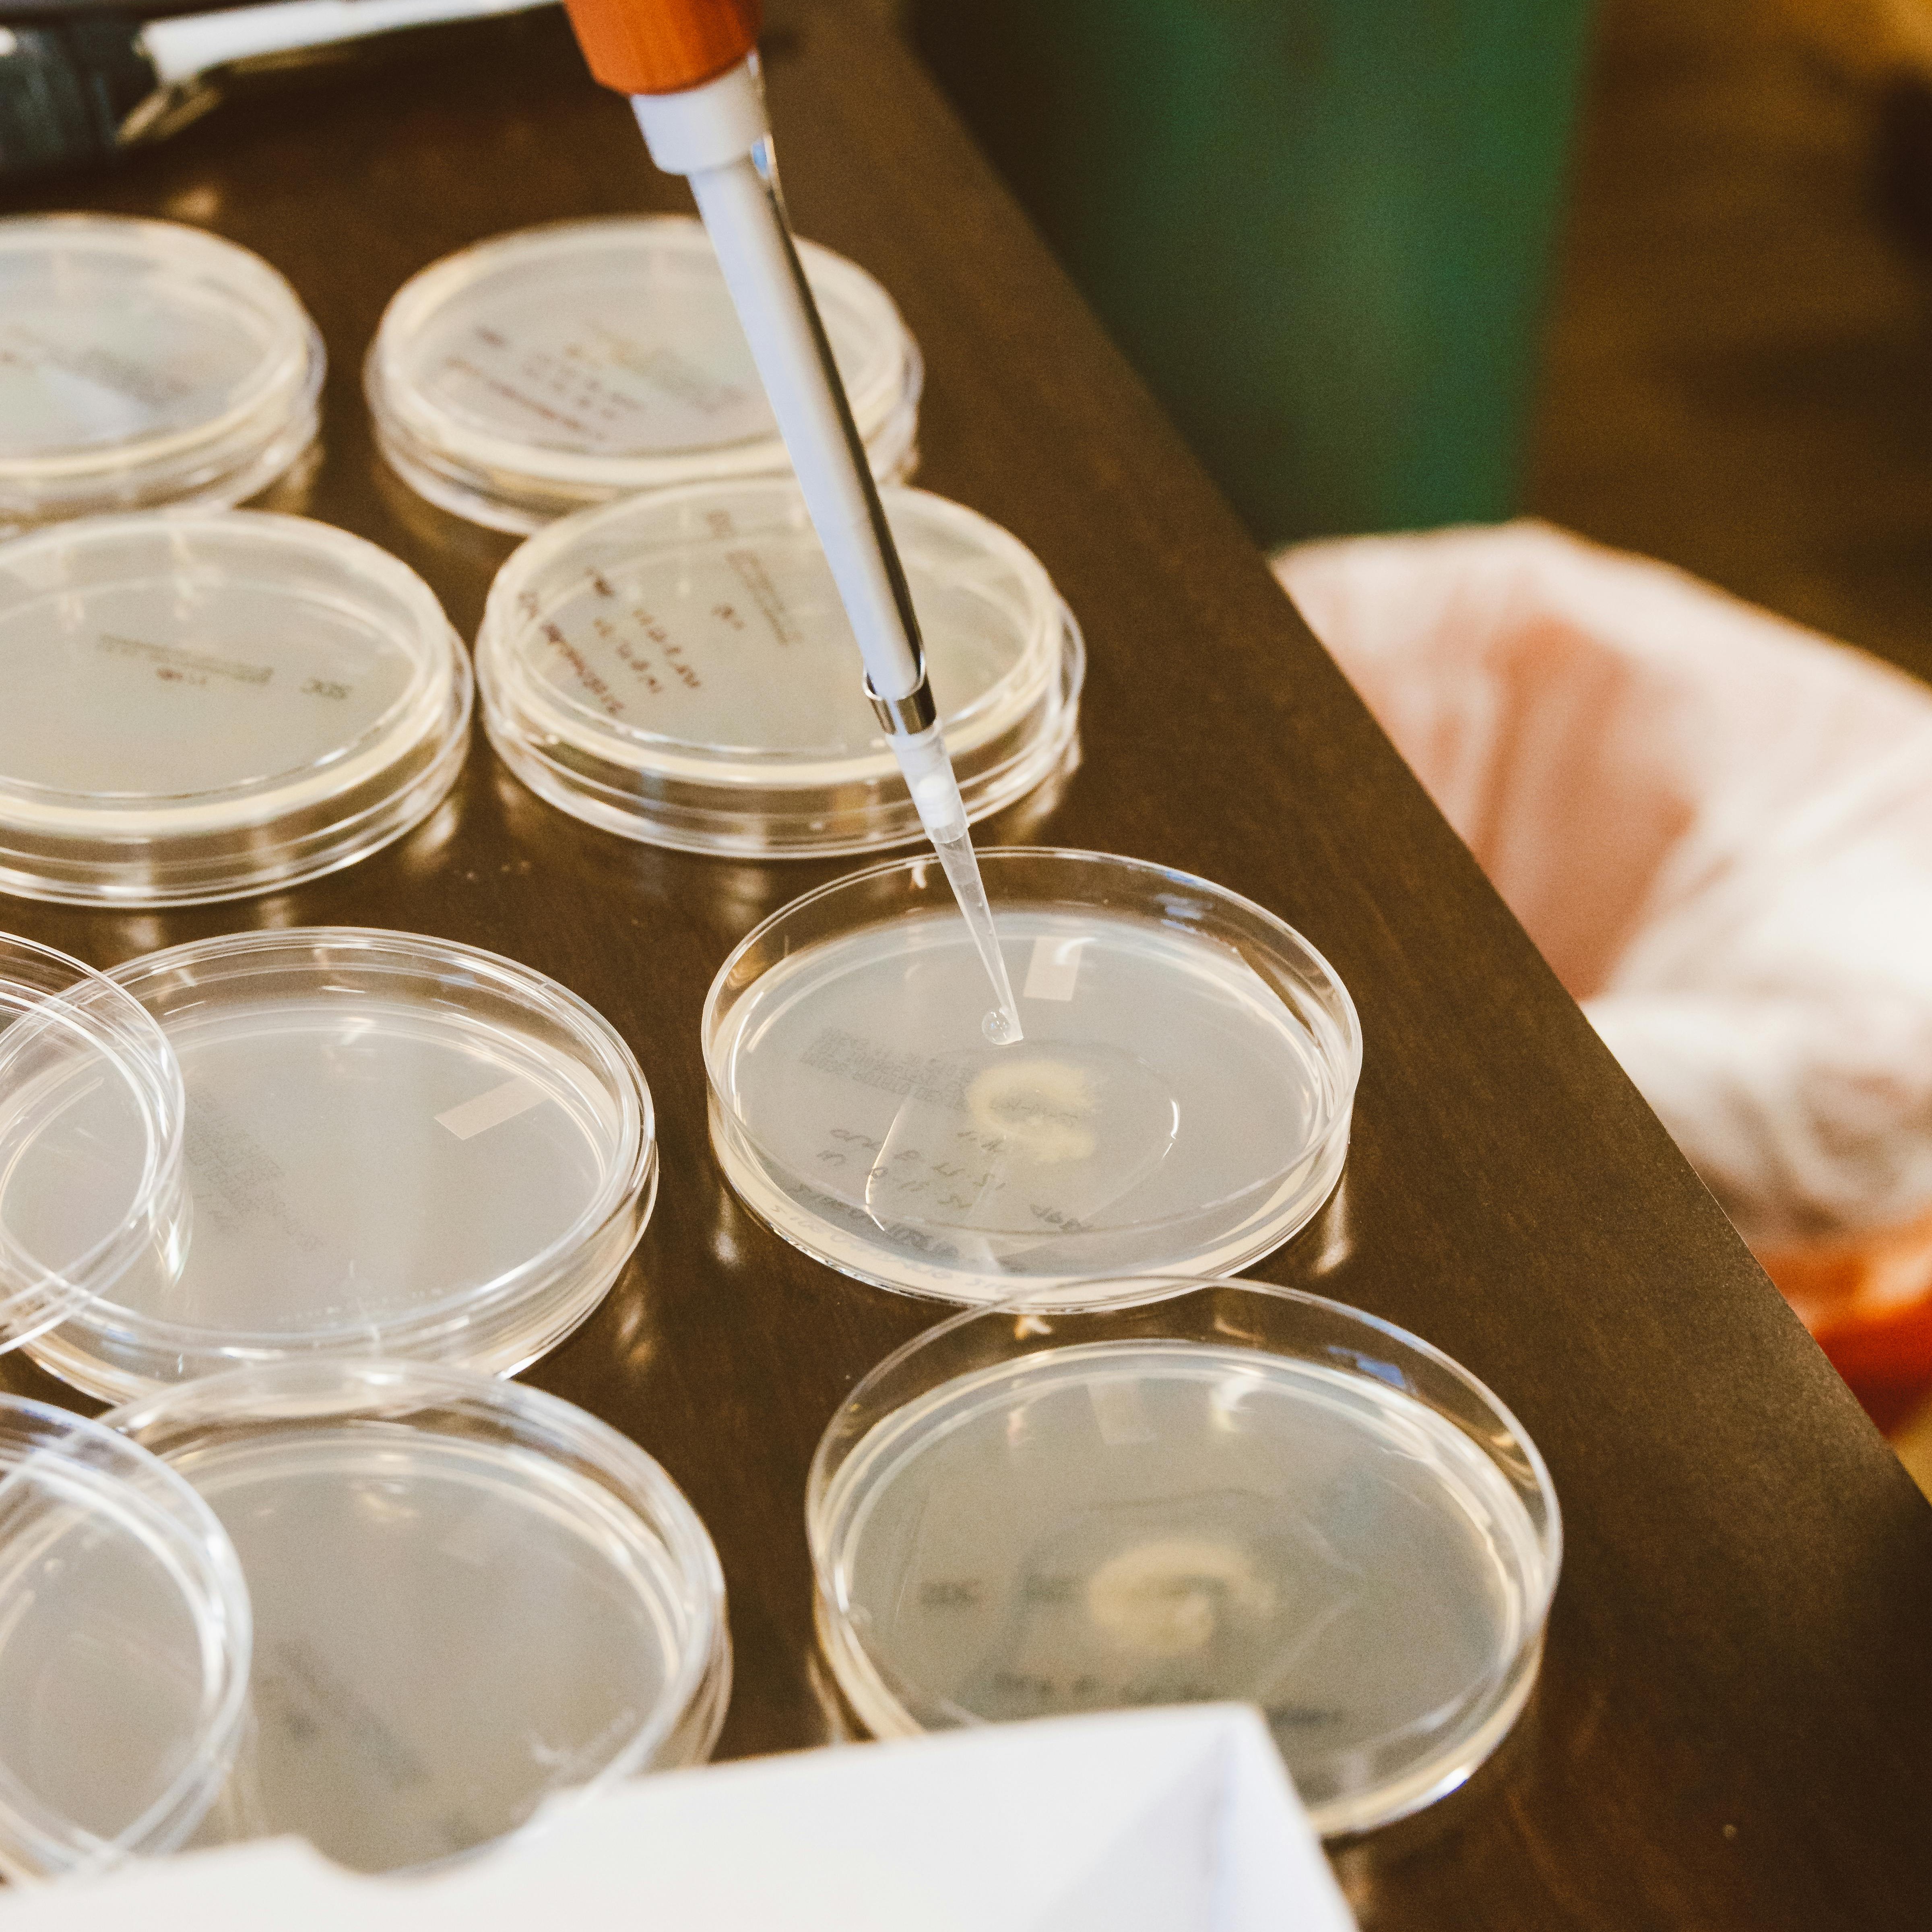

研究中心介绍
深港高等研究交流中心(简称“SHARE”)旨在依托深圳与香港的区位优势和大湾区的优质科研教育资源,搭建跨学科科研合作与国际交流平台。中心聚焦人工智能赋能的前沿科学问题,推动其在生物医药、材料科学、低空经济、无线通信、具身智能等关键领域的应用与突破。中心致力于引入新思想、提出新问题、孕育新方法,通过香港及亚太一流高校、科研机构和深圳本地重点研发单位的紧密合作,积极推动原创成果的落地与产业化转化。
面向未来,SHARE 将汇聚全球科研智慧,构建深港合作新机制,形成 AI 应用新范式,引领科研新潮流。
技术方向



中心运行机制



采用“上游问题引导-核心团队预研-高校联合攻关-成果评审与转化”的模式,确保科研成果与实际应用紧密结合。
上游合作:深圳本地重点科研机构(如深圳医学科学院 SMART、深圳生命科学与能源材料创新研究院 MILES、深圳湾实验室等),提供具体科研问题与数据需求。
下游合作:深港及亚太地区高校(如香港科技大学、香港中文大学、清华大学深圳国际研究生院、新加坡南洋理工大学、首尔大学等),组建跨学科攻关团队。
国际学术委员会:由国内外知名学者组成,对研究方向与成果进行评审,确保公平、公正与学术前瞻性。
核心科研团队:长期稳定,负责中心的学术与科研骨干工作;
访问合作团队:由深港及亚太高校教师、博士后与学生组成,流动参与中心研究;
学术委员会:由国际知名学者组成,对项目指南、资源分配与成果进行评审;
管理团队:负责资金管理、项目申请、专家评审、立项与成果考核。
团队建设与
人才培养
核心团队:由 AI、通信、生物医药、材料等领域的科研骨干组成,保障研究连续性与原创性。
青年人才引进:通过博士后流动站、国际访问学者计划,吸引国内外青年学者加入。
人才培养:依托深港高校平台,培养硕士、博士、博士后,形成高水平科研人才梯队。
学术交流:每年举办国际研讨会,搭建深港与亚太科研人才的交流网络。
负责人
研究中心介绍
深港高等研究交流中心(简称“SHARE”)旨在依托深圳与香港的区位优势和大湾区的优质科研教育资源,搭建跨学科科研合作与国际交流平台。中心聚焦人工智能赋能的前沿科学问题,推动其在生物医药、材料科学、低空经济、无线通信、具身智能等关键领域的应用与突破。中心致力于引入新思想、提出新问题、孕育新方法,通过香港及亚太一流高校、科研机构和深圳本地重点研发单位的紧密合作,积极推动原创成果的落地与产业化转化。
面向未来,SHARE 将汇聚全球科研智慧,构建深港合作新机制,形成 AI 应用新范式,引领科研新潮流。
技术方向

中心运行机制



采用“上游问题引导-核心团队预研-高校联合攻关-成果评审与转化”的模式,确保科研成果与实际应用紧密结合。
上游合作:深圳本地重点科研机构(如深圳医学科学院 SMART、深圳生命科学与能源材料创新研究院 MILES、深圳湾实验室等),提供具体科研问题与数据需求。
下游合作:深港及亚太地区高校(如香港科技大学、香港中文大学、清华大学深圳国际研究生院、新加坡南洋理工大学、首尔大学等),组建跨学科攻关团队。
国际学术委员会:由国内外知名学者组成,对研究方向与成果进行评审,确保公平、公正与学术前瞻性。
核心科研团队:长期稳定,负责中心的学术与科研骨干工作;
访问合作团队:由深港及亚太高校教师、博士后与学生组成,流动参与中心研究;
学术委员会:由国际知名学者组成,对项目指南、资源分配与成果进行评审;
管理团队:负责资金管理、项目申请、专家评审、立项与成果考核。
团队建设与
人才培养
核心团队:由 AI、通信、生物医药、材料等领域的科研骨干组成,保障研究连续性与原创性。
青年人才引进:通过博士后流动站、国际访问学者计划,吸引国内外青年学者加入。
人才培养:依托深港高校平台,培养硕士、博士、博士后,形成高水平科研人才梯队。
学术交流:每年举办国际研讨会,搭建深港与亚太科研人才的交流网络。
负责人
